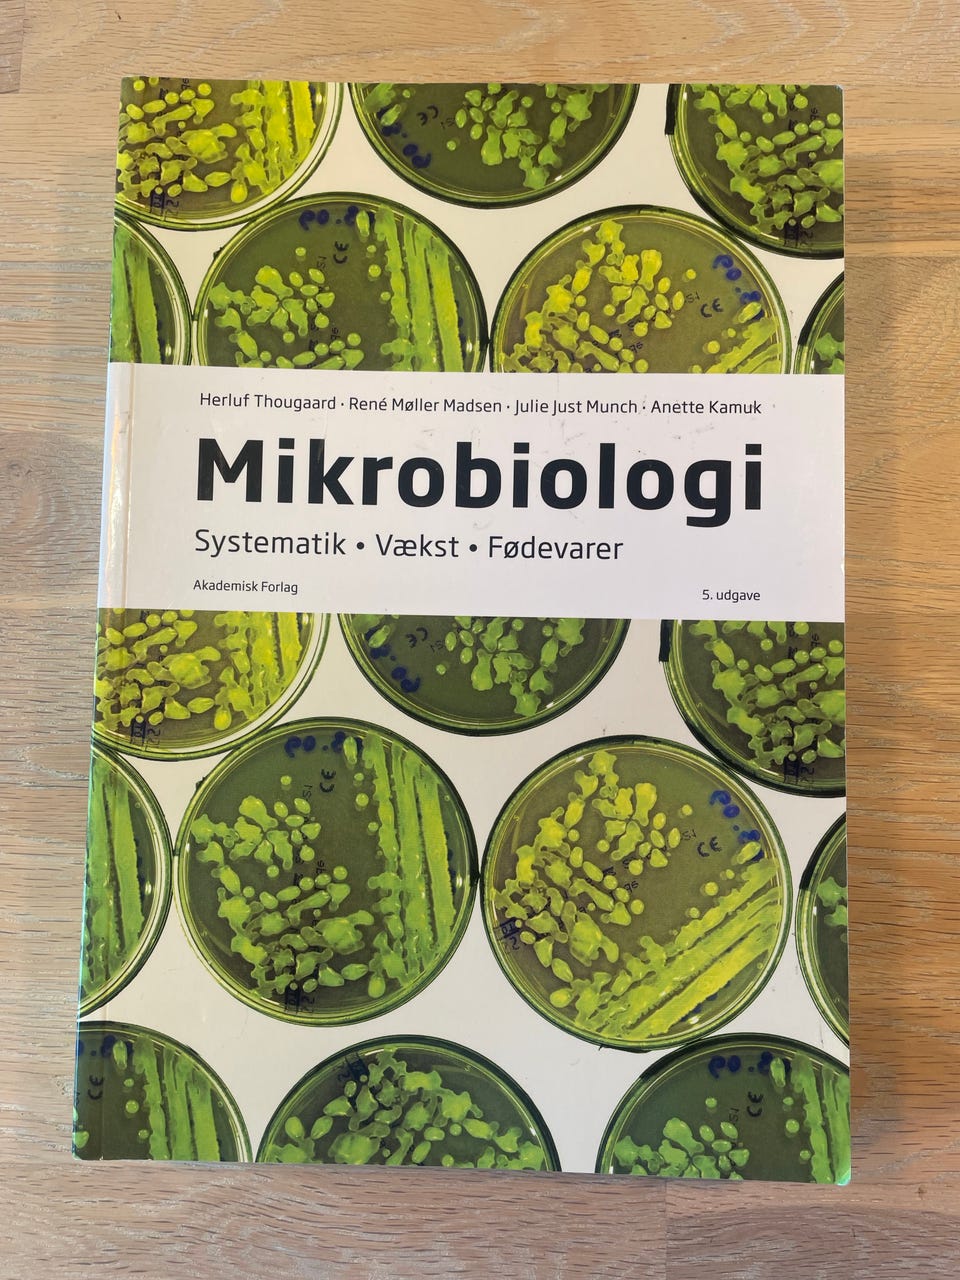
Galleribillede

Billedgalleri
(1/15)
Bøger til Laborant- uddannelsen
Til salg
2.500 kr.
Bed sælgeren om at sende med Fiks færdig! Det er trygt, hurtigt, og varen vil blive sendt til dig. Læs mere
Varebeskrivelse
Stand: Brugt - men i god stand
Emne: Biologi
Hej jeg sælger alle mine bøger samlet.
Bøgerne kan bruges til kommende vinter/ sommerstart og efterfølgende semestre/ kommende år.
Sidste tre billder er billeder af en halv udfyldt Labjounal, hvor alle ens øvelser/ forsøg skal dokumenteres løbende. Man skal have en frisk en fra starten, men denne her ville give en mulig forspring i forhold til andre der starter samtidigt
Hvis man selv skal købe bøgerne osv. fra ny, inden/ under studiestart kan det koste op til 6000kr! Min pris er meget fair selvom det ikke virker sådan
Bemærk: Knappen til at vise den fulde beskrivelse har kun en visuel effekt.
Brugerprofil

Du skal være logget ind for at se brugerprofiler og sende beskeder.
Log indAnnoncens metadata
Sidst redigeret: 21.2.2026 kl. 21:17 ・ Annonce-ID: 15900882